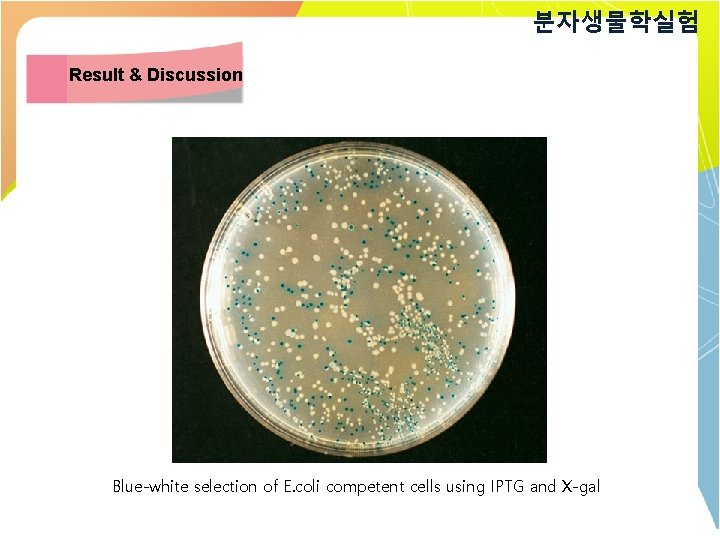
분자생물학실험 Result & Discussion Blue-white selection of E. coli competent cells using IPTG and

SUBJECT Miniprep Restriction Enzyme DNA EXTRACTION PCR TA

분자생물학실험 SUBJECT Mini-prep, Restriction Enzyme

분자생물학실험 DNA EXTRACTION PCR TA Ligation E. coli transformation Mini-prep Restriction enzyme Sequence blast

분자생물학실험 1596 bp 2076 bp Gene 1 3. 0 Kb → 1. 0 Kb → Gene 2


분자생물학실험 Materials & Method • E. coli transformation → Selection
분자생물학실험 Result & Discussion Blue-white selection of E. coli competent cells using IPTG and X-gal

분자생물학실험 Materials & Method • Minipreparation (Mini-prep) Alkaline lysis solution Ⅰ autoclave for 15 min and store at 4℃ Reagent Glucose (MW=198. 2) Tris-Cl (p. H 8. 0) EDTA (p. H 8. 0) conc. 50 m. M 25 m. M 10 m. M Alkaline lysis solution Ⅱ 0. 2 N Na. OH (freshly diluted from a 10 N stock) Prepare Sol 2 fresh and use at room temperature. Reagent Na. OH SDS conc. 0. 2 N 1% Alkaline lysis solution Ⅲ store at 4℃ and transfer it to an ice just before use. Reagent potassium acetate acetic acid D. W. conc. 3 M 7

분자생물학실험 Materials & Method • Minipreparation (Mini-prep) Traditional Method 1. Inoculate the single colony into 5 ml of LB medium containing the antibiotic and incubate the culture overnight at 37℃ with vigorous shaking. 2. Centrifuge at 4000 rpm for 5 min 3. Remove the medium. 4. Re-suspend the pellet in 100 ul SolⅠ by vigorous vortexing. 5. Transfer the re-suspension to new e-tube. 6. Add 200 ul Sol Ⅱ and inverting the tube rapidly five times. 7. Rapidly Add 150 ul of Sol Ⅲ and inverting the tube several times. 8. Store the tube on ice for 3 -5 min. 9. Centrifuge at 13, 000 rpm for 5 min at 4℃(실험에선 25 ℃) 10. Transfer the supernatant into new e-tube and precipitate by 2 volumes of ethanol. 11. Centrifuge at 13, 000 rpm for 5 min at 4℃(실험에선 25 ℃) 12. Remove the supernatant and add 70% Ethanol. 13. Centrifuge at 13, 000 rpm for 2 min at 4℃ (실험에선 25 ℃) 14. Dry the DNA pellet 15. Dissolve DNA in D. W. with 20 ug/ml RNase A 8

분자생물학실험 Materials & Method • Restriction Enzyme insert R F p. TOP TA V 2 9

Lac. ORF 시작 294 bp 295 bp

분자생물학실험 Materials & Method • Restriction enzyme (mixture) Enzyme 2종류사용 10 x Buffer 1㎕ Enzyme (1) 0. 2(~0. 3)㎕ Enzyme (2) 0. 2(~0. 3)㎕ 10 x BSA(1/10) 1㎕ Template 5㎕ DW Up to 10㎕ Total 10㎕ Enzyme 1종류 10 x Buffer 1㎕ Enzyme 0. 5㎕ 10 x BSA(1/10) 1㎕ Template 5㎕ DW Up to 10㎕ Total 10㎕ PCR tube 에 위의 mixture 넣고 37℃ chamber에 1~2 hr 보관

분자생물학실험 Materials & Method • Restriction enzyme (mixture) Enzyme 2종류사용 10 x Buffer IV 1㎕ Enzyme (Nco I) 0. 2(~0. 3)㎕ Enzyme 0. 2(~0. 3)㎕ (Xho I) Control Gene 1 10 x BSA(1/10) 1㎕ Template 5㎕ DW Up to 10㎕ Total 10㎕ Enzyme 1종류 10 x Buffer II 1㎕ 10 x Buffer 1㎕ Enzyme(Sac I) 0. 2(~0. 3)㎕ Enzyme(Eco. R I) 0. 5㎕ 10 x BSA(1/10) 1㎕ Template 5㎕ DW Up to 10㎕ Total 10㎕ PCR tube 에 위의 mixture 넣고 37℃ chamber에 1~2 hr 보관

p. TOP TA V 2 3807 base pairs agcgcccaatacgcaaaccgcctctccccgcgcgttggccgattcattaatgcagctggcacgacaggtttcccgactggaaagcgggcagtgagcgcaacgca attaatgtgagttagctcattaggcaccccaggctttacactttatgcttccggctcgtatgttgtgtggaattgtgagcggataacaatttcacacaggaaaca gctatgaccatgattacgccaagcttggtaccgagctcggatccactagtaacggccgccagtgtgctggaattcgcccttaagggcgaattctgcagatatccatc acactggcggccgctcgagcatctagagggcccaattcgccctatagtgaatcgtattacaattcactggccgtcgttttacaacgtcgtgactgggaaaacc ctggcgttacccaacttaatcgccttgcagcacatccccctttcgccagctggcgtaatagcgaagaggcccgcaccgatcgcccttcccaacagttgcgcagccta tacggcagtttaaggtttacacctataaaagagccgttatcgtctgtttgtggatgtacagagtgatattattgacacgccggggcgacggatggtga tccccctggccagtgcacgtctgctgtcagataaagtctcccgtgaactttacccggtggtgcatatcggggatgaaagctggcgcatgatgaccaccgatatggc cagtgtgccggtctccgttatcggggaagaagtggctgatctcagccaccgcgaaaatgacatcaaaaacgccattaacctgatgttctggggaatataaatgtca ggcatgagattatcaaaaaggatcttcacctagatccttttcacgtagaaagccagtccgcagaaacggtgctgaccccggatgaatgtcagctactgggctatct ggacaagggaaaacgcaagcgcaaagagaaagcaggtagcttgcagtgggcttacatggcgatagctagactgggcggttttatggacagcaagcgaaccg gaattgccagctggggcgccctctggtaaggttgggaagccctgcaaagtaaactggatggctttcttgccgccaaggatctgatggcgcaggggatcaagctc tgatcaagagacaggatgaggatcgtttcgcatgattgaacaagatggattgcacgcaggttctccggccgcttgggtggagaggctattcggctatgactggg cacaacagacaatcggctgctctgatgccgccgtgttccggctgtcagcgcaggggcgcccggttctttttgtcaagacctgtccggtgccctgaact gcaagacgaggcagcgcggctatcgtggccacgacgggcgttccttgcgcagctgtgctcgacgttgtcactgaagcgggaagggactggctgctattg ggcgaagtgccggggcaggatctcctgtcatctcaccttgctcctgccgagaaagtatccatcatggctgatgcaatgcggcggctgcatacgcttgatccggcta cctgcccattcgaccaccaagcgaaacatcgagcgagcacgtactcggatggaagccggtcttgtcgatcaggatgatctggacgaagagcatcaggg gctcgcgccagccgaactgttcgccaggctcaaggcgagcatgcccgacggcgaggatctcgtcgtgacccatggcgatgcctgcttgccgaatatcatggtgg aaaatggccgcttttctggattcatcgactgtggccggctgggtgtggcggaccgctatcaggacatagcgttggctacccgtgatattgctgaagagcttggcg gcgaatgggctgaccgcttcctcgtgctttacggtatcgccgctcccgattcgcagcgcatcgccttcttgacgagttcttctgaattgaaaaaggaa gagtattcaacatttccgtgtcgcccttattcccttttttgcggcattttgccttcctgtttttgctcacccagaaacgctggtgaaagtaaaagatgctgaaga tcagttgggtgcacgagtgggttacatcgaactggatctcaacagcggtaagatccttgagagttttcgccccgaagaacgttttccaatgatgagcacttttaaag ttctgctatgtggcgcggtattatcccgtattgacgccgggcaagagcaactcggtcgccgcatacactattctcagaatgacttggttgagtactcaccagtcaca gaaaagcatcttacggatggcatgacagtaagagaattatgcagtgctgccataaccatgagtgataacactgcggccaacttctgacaacgatcggagga ccgaaggagctaaccgcttttttgcacaacatgggggatcatgtaactcgccttgatcgttgggaaccggagctgaagccataccaaacgacgagcgtga caccacgatgcctgtagcaatggcaacaacgttgcgcaaactattaactggcgaactactctagcttcccggcaacaattaatagactggaggcggat aaagttgcaggaccacttctgcgctcggcccttccggctggtttattgctgataaatctggagccggtgagcgtgggtctcgcggtatcattgcagcactgg ggccagatggtaagccctcccgtatcgtagttatctacacgacggggagccaggcaactatggatgaacgaaatagacagatcgctgagataggtgcctcactg attaagcattggtaactgtcagaccaagtttactcatatatactttagatttaaaacttcatttttaaaaggatctaggtgaagatcctttttgataatctcatg accaaaatcccttaacgtgagttttcgttccactgagcgtcagaccccgtagaaaagatcaaaggatcttcttgagatcctttttttctgcgcgtaatctgctgcttgca aacaaaaaaaccaccgctaccagcggtggtttgccggatcaagagctaccaactctttttccgaaggtaactggcttcagcagagcgcagataccaaatact gttcttctagtgtagccgtagttaggccaccacttcaagaactctgtagcaccgcctacatacctcgctctgctaatcctgttaccagtggctgctgccagtggcgata agtcgtgtcttaccgggttggattcaagacgatagttaccggataaggcgcagcggtcgggctgaacggggggttcgtgcacacagcccagcttggagcgaac gacctacaccgaactgagatacctacagcgtgagctatgagaaagcgccacgcttcccgaagggagaaaggcggacaggtatccggtaagcggcagggtcg gaacaggagagcgcacgagggagcttccagggggaaacgcctggtatctttatagtcctgtcgggtttcgccacctctgacttgagcgtcgatttttgtgatgctc gtcaggggggcggagcctatggaaaaacgccagcaacgcggcctttttacggttcctggccttttgctcacatgttctttcctgcgttatcccctgat tctgtggataaccgtattaccgcctttgagctgataccgctcgccgcagccgaacgaccgagcgcagcgaatcagtgagcgaggaagcggaag

Gene 2 (2076 bp) ATGGCGGAATCCGGCGATTTCAACGGTGGTCAACCTCCTCCTCATAGTCCTCTGAGAACAACTTCTTCCGGTAGTA GCAGCAGCAACAACCGTGGTCCTCCTCCTCCTTTAGTGATGGTGAGAAAAAGATTAGCTTCCGA GATGTCTTCTAACCCTGACTACAACAACTCCTCTCGTCCTCCTCGCCGTGTCTCTCACCTTCTTGACTCCAACTACAA TACTGTCACACCACAACAACCACCGTCTCTTACGGCGGCGGCTACTGTATCTTCTCAACCAAACCCACCACTCTCTG TTTGTGGCTTCTCTGGTCTTCCCGTTTTTCCTTCAGACCGTGGTGGTCGGAATGTTATGATGTCCGTACAACCAATGG ATCAAGACTCTTCATCTTCTTCTGCTTCACCTACTGTATGGGTTGACGCCATTATCAGAGACCTTATCCATTCCTCAA CTTCAGTCTCTATTCCTCAACTTATCCAAAACGTTAGAGACATTATCTTCCCTTGTAACCCAAATCTCGGTGCTCTTCT TGAATACAGGCTCCGATCTCTCATGCTCCTTGATCCTCTTCCTCTGACCCTTCTCCTCAAACTTTCGAACCTCTC TATCAGATCTCCAACAATCCTTCTCCTCCACAACAGCAGCACCAACAACAACAGCATAAGCCTC CTCCTCCTCCGATTCAGCAGCAAGAGAAAATTCTTCTACCGATGCACCACCGCAACCAGAGACAGTGACGG CCACTGTTCCCGCCGTCCAAATACGGCGGAGGCTTTAAGAGGAAGAGATTAAGAGGCAGAAG CAAGACGAAGAAGGATTACACCTTCTCACATTGCTGCTACAGTGTGCTGAAGCTGTCTCTGCTGATAATCTCGAAG AAGCAAACAAGCTTCTTCTTGAGATCTCTCAGTTATCAACTCCTTACGGGACCTCAGCGCAGAGAGTAGCTGCTTAC TTCTCGGAAGCTATGTCAGCGAGATTACTCAACTCGTGTCTCGGAATTTACGCGGCTTTGCCTTCACGGTGGATGCC TCAAACGCATAGCTTGAAAATGGTCTCTGCGTTTCAGGTCTTTAATGGGATAAGCCCTTTAGTGAAATTCTCACACTT TACAGCGAATCAGGCGATTCAAGAAGCATTTGAGAAGACAGTGTACACATCATTGACTTGGACATCATGCA GGGACTTCAATGGCCTGGTTTATTCCACATTCTTGCTTCTAGACCTGGAGGACCTCCACACGTGCGACTCACGGGA CTTGGTACTTCCATGGAAGCTCTTCAGGCTACAGGGAAACGTCTTTCGGATTTCGCAGATAAGCTTGGCCTTT TGAGTTCTGCCCTTTAGCTGAGAAAGTTGGAAACTTGGACACTGAGAGACTCAATGTGAGGAAAAGGGAAGCTGT GGCTGTTCACTGGCTTCAACATTCTCTTTATGATGTCACTGGCTCTGATGCACACACTCTCTGGTTACTCCAAAGgtaa aataaacattaccttttaatcactctttatctataaattattttaagattatataggaaagatatgttctaaaaagtggcttttttggttaatgattggggaatg aacag. ATTAGCTCCTAAAGTTGTGACAGTAGTGGAACAAGATTTGAGCCACGCTGGTTCTTAGGAAGATTTGTA GAAGCAATACATTACTACTCTGCACTCTTTGACTCACTGGGAGCAAGCTACGGCGAAGAGAGTGAAGAGAGACAT GTCGTGGAACAGCAGCTATTATCGAAAGAGATACGGAATGTATTAGCGGTTGGAGGACCATCGAGAAGCGGTGAAGTTTGAGAGCTGGAGAAAATGCAACAATGTGGGTTTAAAGGTATATCTTTAGCTGGAAATGCAGCT ACACAAGCGACTCTACTGTTGGGAATGTTTCCTTCGGATGGTTACACTTTGGTTGATGATAATGGTACACTTAAGCT TGGAAAGATCTTTCGTTACTCACTGCTTCAGCTTGGACGCCTCGTTCTTAG

GENE 1 (1596 bp) ATGGATACTCTCTTTAGACTAGTCTCCAACAACAATCCGATAGTATCATTACA AATCTTCGTTAAGCAGAACTTCCACCACCACTACTGGCTCTCCACAAACTGCTTATCACT ACAACTTTCCACAAAACGACGTCGTCGAAGAATGCTTCAACTTTTTCATGGATGAAGAAGACC TTTCCTCTTCTCACCACAACCATCACAACAATCCTAATACTACTCTCCT TTCACTACTCCCAATACCATCCCGCCACATCATCAACCCCTTCCTCCACCGCCGCAGCC GCAGCTTTAGCCTCGCCTTACTCCTCCTCCGGCCACCATAATGACCCTTCCGCGTTCTCCATAC CTCAAACTCCTCCGTCCTTCGACTTCTCAGCCAATGCCAAGTGGGCAGACTCGGTCCTTCTTG AAGCGGCACGTGCCTTCTCCGACAAAGACACTGCACGTGCGCAACAAATCCTATGGACGCTC AACGAGCTCTCTTCTCCGTACGGAGACACCGAGCAAAAACTGGCTTCTTACTTCCTCCAAGCT CTCTTCAACCGCATGACCGGTTCAGGCGAACGATGCTACCGAACCATGGTAACAGCTGCAGC CACAGAGAAGACTTGCTCCTTCGAGTCAACGCGAAAAACTGTACTAAAGTTCCAAGAAGTTA GCCCCTGGGCCACGTTTGGACACGTGGCGGCAAACGGAGCAATCTTGGAAGCAGTAGACGG AGAGGCAAAGATCCACATCGTTGACATAAGCTCCACGTTTTGCACTCAATGGCCGACTCTTCT AGAAGCTTTAGCCACAAGATCAGACGACACGCCTCACCTAAGGCTAACCACAGTTGTCGTGG CCAACAAGTTTGTCAACGATCAAACGGCGTCGCATCGGATGATGAAAGAGATCGGAAACCG AATGGAGAAATTCGCTAGGCTTATGGGAGTTCCTTTCAAATTTAACATTATTCATCACGTTGGA GATTTATCTGAGTTTGATCTCAACGAACTCGACGTTAAACCAGACGAAGTCTTGGCCATTAAC TGCGTAGGCGCGATGCATGGGATCGCTTCACGTGGAAGCCCTAGAGACGCTGTGATATCGAG TTTCCGACGGTTAAGACCGAGGATTGTGACGGTCGTAGAAGAAGAAGCTGATCTTGTCGGAG AAGAAGAAGGTGGCTTTGATGATGAGTTCTTGAGAGGGTTTGGAGAATGTTTACGATGGTTTA GGGTTTGCTTCGAGTCATGGGAAGAGAGTTTTCCAAGGACGAGCAACGAGAGGTTGATGCTA GAGCGTGCAGCGGGACGTGCGATCGTTGATCTTGTGGCTTGTGAGCCGTCGGATTCCACGGA GAGGCGAGAGACAGCGAGGAAGTGGTCGAGGAGGATGAGGAATAGTGGGTTTGGAGCGGT GGGGTATAGTGATGAGGTGGCGGATGATGTCAGAGCTTTGTTGAGGAGATATAAAGAAGGT GTTTGGTCGATGGTACAGTGTCCTGATGCCGCCGGAATATTCCTTTGTTGGAGAGATCAGCCG GTGGTTTGGGCTAGTGCGTGGCGGCCAACGTAA

분자생물학실험 Materials & Method • restriction enzyme site 찾는 법을 사용하여 size예측 294 bp 0 1267 295 bp 0 295 bp 294 bp 1267 346 Gene 1: 2076 bp Vector: 3807 bp Xba 1 - insert: cut at 1267 bp - vector: cut at 346 bp Insert의 방향이 정방향 Band size: 860 bp / 5023 bp Insert의 방향이 역방향 Band size: 1318 bp / 4565 bp 2013 -10 -17

분자생물학실험 Materials & Method • restriction enzyme site 찾는 법을 사용하여 size예측 294 bp 0 630 295 bp 630 310 356 Insert의 방향이 정방향 Band size: 46 bp/ 981 bp / 4375 bp 0 295 bp 294 bp Gene 2: 1596 bp Vector: 3807 bp Pst 1 - insert: cut at 630 bp - vector: cut at 310 bp Apa 1 - vector: cut at 356 bp 2013 -10 -17 Insert의 방향이 역방향 Band size: 46 bp/ 645 bp / 4711 bp

분자생물학실험 Materials & Method • Restriction Enzyme Double Address: http: //pga. mgh. harvard. edu/web_apps/web_map/start 18

분자생물학실험 Materials & Method 19

분자생물학실험 Materials & Method 20

분자생물학실험 Materials & Method Red: one cut Blue: more than one cut 2013 -10 -10

분자생물학실험 Materials & Method

분자생물학실험 Materials & Method • Restriction Enzyme Double 23

분자생물학실험 Result & Discussion • Miniprep solution Ⅰ, Ⅱ, Ⅲ 에 들어가는 시약의 역할, 왜 필요한지? 원리 • Miniprep solution Ⅰ, Ⅱ, Ⅲ ( 아래 표 완성 ) Alkaline lysis solution Ⅰ Reagent Final conc. Stock conc. Glucose (MW=198. 2) 50 m. M powder Tris-Cl (p. H 8. 0) 25 m. M 1 M ml EDTA (p. H 8. 0) 10 m. M 0. 5 M ml Total Volume g 100 ml

분자생물학실험 Result & Discussion Alkaline lysis solution Ⅱ Reagent Final conc. Stock conc. Na. OH 0. 2 N 10 N ml SDS 1% 10% ml Total Volume 100 ml Alkaline lysis solution Ⅲ Reagent Final conc. Stock conc. potassium acetate 3 M 5 M acetic acid 99. 9% Volume ml 11. 5 ml D. W. Total 100 ml

분자생물학실험 Result & Discussion 1. 수업시간에 배웠던 restriction enzyme site 찾는 법을 사용하여 size 예측 Insert Gene 1 Enzyme 1개 Control Enzyme 2개 사용한 Enzyme 잘려지는 위치 예상되는 band size Insert: Vector:

분자생물학실험 Result & Discussion 2. 새로운 restriction enzyme site를 찾고 enzyme 이름 및 잘리는 위치, 결과로 확인 될 band size예측 (표 아래에 Enzyme선택이유 (ex, 정방향, 역방향, band 확인 시) 쓰기) Insert Gene 1 Enzyme 1개 Gene 2 Enzyme 2개 Enzyme 1개 Enzyme 2개 사용한 Enzyme 잘려지는 위치 Insert: Vector: 예상되는 band size 3. Restriction enzyme을 사용할 때 몇몇 enzyme들은 BSA를 필요로 한다. BSA 의 역할 조사

- Slides: 28